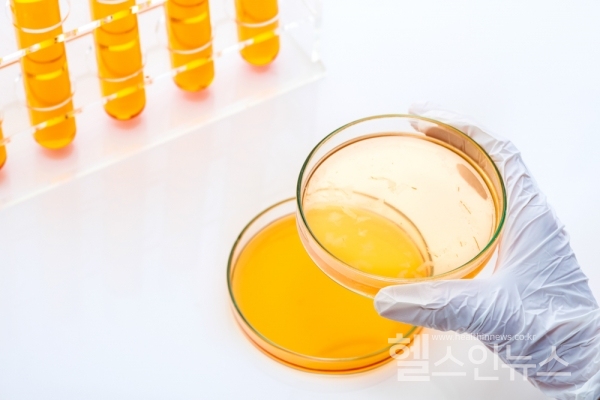
2020년도 보건복지부 연구개발(R&D) 예산 5,278억 원 지원, 투자 방향 담은 통합시행계획 확정

2019년 제4차 보건의료기술정책심의위원회 개최 (12.16)
보건복지부(장관 박능후)는 바이오헬스 산업 혁신 및 국민 보건의료 문제 해결을 위한 투자 강화 등 2020년 연구개발(R&D) 투자 방향을 담은 ”2020년도 보건복지부 R&D사업 통합 시행계획”을 12월 16일(월) 제4차 보건의료기술정책심의위원회(위원장 송시영 연세대학교 의과대학 교수)에서 심의·확정했다고 밝혔다.
내년 보건복지부 주요 R&D 예산*은 올해 예산(총 4,669억 원) 대비 13.0%(609억 원) 늘어난 5,278억 원이다.
* 전체 R&D 예산 중 기관운영비, 국립병원 연구비 등 일반 R&D 예산 제외
시행계획 대상 사업은 범부처전주기의료기기연구개발, 치매극복연구개발, 감염병예방·치료기술개발 등 총 52개 사업으로, 신규과제 1,495억 원, 계속과제 3,783억 원을 지원할 계획이다.
내년 보건복지부 주요 R&D 사업은 바이오헬스 산업을 우리나라 차세대 주력산업으로 육성하고자 지난 5월에 발표한 ‘바이오헬스 산업 혁신전략’을 반영*하여,
* 바이오헬스 분야 정부 R&D 투자를 ’25년까지 4조 원 이상으로 확대 추진
‘바이오헬스 산업 발전으로 사람 중심 혁신성장 실현 및 공익적 R&D 투자 강화로 국민 보건의료 문제 해결’을 목표로 추진한다.
보건복지부는 ‘바이오헬스산업 육성을 위한 혁신적인 유망기술의 전략적 투자 요구’와 ‘지속가능한 보건복지를 위한 공익적 연구 필요성에 대한 공감 확대’ 등 보건의료 R&D 정책 여건에 따라, 4대 추진전략*과, 7대 중점 추진방향을 토대로 2020년 주요 R&D를 추진해 나갈 계획이다.
* ① 바이오헬스 산업 혁신, ② 공익적 R&D 투자 강화, ③ 병원 기반 연구생태계 조성, ④ 소재·부품·장비 국산화 지원
① 바이오헬스 산업 혁신
바이오헬스 산업의 육성을 위하여 혁신 신약·의료기기·재생의료 등 차세대 유망기술을 중점 지원하고(총 1,281억 원 중 신규과제 592억 원), 100만 명 규모 ‘국가 바이오 빅데이터’ 구축, 인공지능, 정밀의료 등 4차 산업혁명 기반 의료기술을 적극 지원한다(총 588억 원 중 신규과제 51억 원).
② 공익적 R&D 투자 강화
신·변종 감염병, 치매, 정신질환 등 사회문제 해결을 위한 진단·치료기술 개발 및 지역사회 적용·확산을 수행하는 한편(총 1,041억 원 중 신규과제 230억 원), 의료취약계층의 재활ㆍ돌봄 서비스 및 만성질환, 생애주기별 건강관리를 위한 서비스 모델 개발 등 의료비 절감과 예방 중심 건강관리를 위한 국민 건강증진 R&D를 수행한다(총 1,022억 원 중 신규과제 214억 원).
③ 병원 기반 연구생태계 조성
산·학·연·병이 활용할 수 있는 병원 중심의 공동연구 기반(플랫폼) 구축 등 병원을 연구 생태계 혁신거점으로 집중 육성하고(총 674억 원 중 신규과제 100억 원), 해외 우수 연구기관과 연계 및 임상의사와 연구자·기업 간 협업 연구 지원 등 혁신성장을 견인할 보건의료 핵심 인재를 양성한다(총 192억 원 중 신규과제 17억 원).
④ 소재·부품·장비 국산화 지원
해외 의존성이 높은 백신의 자체개발, 수입 의존 화장품 기초소재와 노인·장애인 보조기기 등 국산화 지원을 강화한다(총 448억 원 중 신규과제 291억 원).
보건복지부 임인택 보건산업정책국장은 이날 보건의료기술정책심의위원회에서 “정부는 질병 극복을 통해 국민의 건강을 증진시키고, 바이오헬스 산업 육성으로 세계 시장을 선도할 수 있도록 바이오헬스 분야 R&D 투자를 꾸준히 확대해 나갈 방침”이라고 밝혔다.
또한 “보건의료 R&D의 성과가 하루빨리 국민 건강 증진과 삶의 질 향상으로 이어질 수 있도록 현장에서 미충족 수요 발굴과 적극적인 연구를 부탁드린다“고 전했다.
2020년 보건복지부 R&D 사업은 올해 12월 20일(금) 즈음 사업 공고* 예정이며, 자세한 사항은 ‘보건의료기술 종합정보시스템’ 누리집(https://www.htdream.kr)에서 확인할 수 있다.
* 일부 사업은 제외되며, 일정 변동 가능
현혜정 기자
hyejung@healthinnews.co.kr


